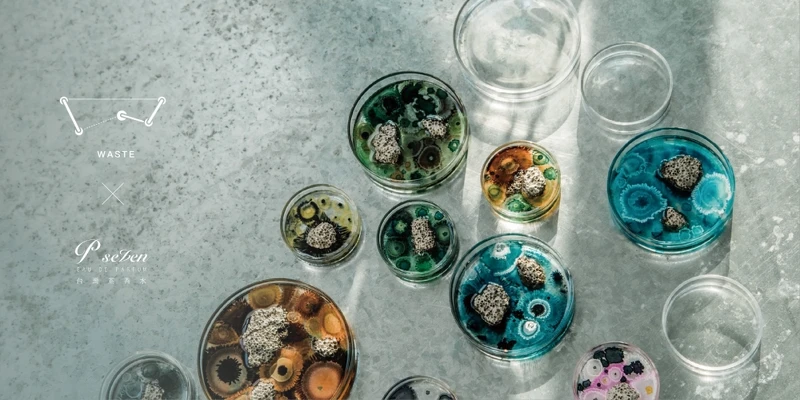

原來嗅覺對我們影響這麼大

你知道嗎?五感當中,「嗅覺」是唯一可直接影響大腦中樞神經的感官,牽動著我們的情緒、記憶與認知行為。也因為感官跟生存本能息息相關,所以人們對於各式不同香氣的反應,都透露著身體所釋放的訊息。
也就是在聞精油時,如果你對某個味道特別喜歡或有感,代表身體目前正需要這些芳香因子的療癒作用,日常不妨藉由對香氣的感受探索內在,適時給予身心支持與陪伴、補給正面能量。
2021精油新品推薦
AROMATHERAPY ASSOCIATES經典純香精油

AROMATHERAPY ASSOCIATES純香精油是100%天然調和的純香精油。透過蒸餾、壓榨..等手法,萃取自產地最純粹的芳香植物,讓純淨的天然芳香分子,透過嗅吸呵護身體的需求。於空間內添上清新怡人自然香氣,身心靈便能隨時處在最佳狀態。這次全新登場共推出五款。
1.晚間舒緩Deep Relax

深度放鬆、靜心舒眠。
主要成份:岩蘭草、洋甘菊、檀木
2.明煥Revive

主要成份:葡萄柚、佛手柑、橙花
3.呼吸Breathe

清新、潔淨
主要成份:桉樹、薄荷、茶樹、松木
4.心靈之沐Forest Therapy

減壓舒心、恢復活力
主要成份:絲柏、芳樟、粉紅胡椒
5.怡神De-Stress

主要成份:乳香、野洋甘菊、苦橙葉
建議使用方式
水氧機、香薰儀/隨身攜帶嗅吸/毛巾、帕巾香薰/足浴/滴入消毒酒精/滴入基底油調配。
Oui Organic有機單方精油新品

唯有機旗下自創品牌Oui Organic 2021年秋冬全新推出五款通過歐盟ECOCERT有機認證的有機單方精油(尤加利、白千層、乳香、葡萄柚及依蘭依蘭),讓品牌精油擴增至13款。全系列強調皆於法國製造,以100%有機植物精華萃取,香氣濃郁自然,每一款香氣的獨特的氣息和功效,讓生活的美好再升級。
1.葡萄柚單方精油

香氣清新甜美,如陽光般充滿活力感,加入香氛儀薰香不僅幫助放鬆紓壓,還可以去除空氣異味,也推薦與具有鼓舞精神功效的檸檬精油搭配。
2.尤加利單方精油

選用澳洲尤加利,為尤加利中最溫和的品種,安全性較高,適合長期的日常保養,還可與基底油搭配使用於肌膚保養。尤加利也適合添加於各式清潔用品中,有助於去除異味。
3.白千層單方精油

將白千層、尤加利或茶樹精油加於擴香儀中,讓植物天然淨化空氣,加強防護。Oui Organic白千層單方精油氣味舒爽,帶有微微的樟腦香氣,可幫助暢通呼吸、集中精神。
4.依蘭依蘭單方精油

以蒸汽蒸餾法萃取,將花朵的甜美香氣完整保留,依蘭依蘭又稱為香水樹,花香味濃郁迷人,可與佛手柑、甜橙、葡萄柚等精油調和薰香,帶出豐富層次感,為生活增添浪漫氛圍。
5.乳香單方精油

香氣淡雅並散發天然木頭香,可以靜心撫慰。睡前泡澡時滴入放鬆紓壓,也適合於睡前冥想時薰香,幫助心靈平靜。此外,有精油之王之稱的乳香精油,,對於肌膚保養有很大的益處,平時可以適量添加於日常保養的乳液或是護手霜中。
延伸閱讀:
BLOOMY LOTUS配方精油

源自紐約的BLOOMY LOTUS 2021年首度推出精油系列,以複方為主。這些精油不僅具備美國USDA有機認證,更嚴謹到通過多項品質安全測試,而且是逐批測試,不是一次通過就好,包含檢視精油純度的GC-MS測試、確保精油未使用基底油稀釋的FAME測試,以及查驗無添加合成成份的對掌測試。確保每瓶複方精油均為100%純淨天然。
配方精油針對現代人的生活需求打造出思緒清晰、活力充沛兩款。另外甚至有為兒童設計的專屬三款精油。

B01思緒清晰配方精油-專為促進平和寧靜的心境而設計,使人放鬆的薰衣草,融合香、羅馬洋甘菊,並以清新的馬鬱蘭與波旁天竺葵氣息加以點綴,幫助放鬆心情,拋開不必要的擔憂,用從容的態度面對生活中的各式挑戰。
B02活力充沛配方精油 -血橙、檸檬與薄荷上揚的舒爽氣息能活絡感官,結合予人溫暖力量的薑精油,於能量低落時提供額外的補給,營造充滿活力的氣氛,鼓舞身心、激發新思路。

K01全神貫注寶貝配方精油-添加苦橙葉、佛手柑、大西洋雪松、薰衣草及岩蘭草等精油,散發鎮定、沉穩的氣息,當外在環境出現較多紛擾時,打造出提升專注力的氛圍。
K02 頭好壯壯寶貝配方精油-舒緩而振奮人心的香氣,來自於雲杉、馬鬱蘭、薰衣草、沼澤 茶樹與檸檬等精油,給予支持和保護的力量、穩固身心,使感官更舒暢。
K03 一夜甜睡寶貝配方精油-柑橘、紅桔甜美舒緩的氣味,與薰衣草和洋甘菊的淡雅花香相呼應,呈現出恬靜氣息,特別推薦於睡前使用,幫助促進幸福放鬆感,締造甜美安穩夢境。
Jurlique芳香精油系列重磅回歸

Jurlique在南澳阿德雷德打造了純淨無汙染的有機農莊,以活機農耕法培育多種珍貴芳香植物,也萃取出符合品牌嚴格要求的高品質精油,一共推出7款在2021年重新回歸,讓生活無時無刻、隨時隨地都可以擁抱最純淨的大自然芬芳。系列包括六款單方與一款複方。
單方精油六款為:
尤加利精油-刺激而甜淡的木香味,帶來醒腦與安定的感覺。
天竺葵精油-綜合強烈的甜味與玫瑰的複合香氛,聞來清新提神。
葡萄柚精油-香甜清爽的果香味,幫助提神醒膚。
薰衣草精油-香甜花草香味,舒緩而清新的作用
薄荷精油-香味清涼,甦醒感十足。
茶樹精油-強烈的香氣,帶有潔淨力。
愜意舒心複方精油則主打在香氛中享受悠閒時光。
2021擴香機、香氛機新品
有了精油,當然不能缺少工具,可以利用擴香機、擴香座讓精油香氣更好的瀰漫在空氣中。
BLOOMY LOTUS Lava Rock火山岩擴香石

2021 歲末之際,BLOOMY LOTUS推出兩款薰香器具,一款就是Lava Rock 火山岩擴香石。手工製作的陶瓷盒身搭配上蓋閃耀的金色塗漆,寫意表現出BLOOMY LOTUS獨到的工藝美學。中心則搭配帶有原始大地能量的火山石,毋需加水或插電,只要將喜愛的精油適量滴在火山岩擴香石上,天然擴香孔洞即可使精油芳香因子自然擴散,輕鬆營造自在恬適的氛圍環境。一、兩滴精油香氣可持續二至四小時。
BLOOMY LOTUS ZEN禪隨身負離子擴香儀

BLOOMY LOTUS另一款新品,結合無水香氛儀、專利 HEPA 濾網、負離子淨化功能打造而成,一機三用。感受精油芬芳香氣時,內部的風扇設計增強負離子淨化範圍與效率。每秒產生逾 1,900萬/cm3負離子,經日本國家機構認證,可以過濾空氣中99.9%的微小顆粒、花粉粉塵。僅需於火山石過濾網上加入三至五滴喜愛的精油,便可輕鬆擁有清新且芬芳的氣息。90g 小巧便攜的時尚簡約機身,不論放在居家環境,或是辦公室、汽車內都很適合。
BLOOMY LOTUS Leaf葉超音波香氛儀

BLOOMY LOTUS擅長從自然界找靈感,結合當代設計,轉化為融入生活環境的薰香工具,2021就以「荷葉」為形象, 推出Leaf 葉超音波香氛儀。霧面絲滑觸感的金屬機身、搭配LED多色光柱水霧,將大自然之美與香氛完美結合。特別適合新北歐風格或是工業風格的居家空間使用。
BLOOMY LOTUS Pebble隨身美肌香氛儀 2.0
同時,BLOOMY LOTUS也在2021年將備受青睞的Pebble隨身美肌香氛儀與Bamboo無水擴香儀升級再進化,推出Pebble隨身美肌香氛儀2.0、Bamboo無水擴香儀2.0。以使用靈活度更高的全新充電機型,換上時尚新色包裝,令香氛器具融入各式居家環境,使用時毋須受限插座位置。

Pebble隨身美肌香氛儀2.0採用予人沉靜感受的鵝卵石為發想設計,象牙白機身、絲滑觸感與圓潤的流線造型,便於手持使用。不僅可擴香,也可當作隨身美容儀,添加進化妝水或調理液後,利用超聲波高速震盪技術,藉由每秒鐘超過15萬次的高頻率震盪,將化妝水或調理液中的水分子昇華為更易於肌膚吸收的小分子細緻冷霧。
延伸閱讀:
BLOOMY LOTUS Bamboo無水擴香儀2.0

充電式設計機型打造更便利使用體驗,告別插座與線路的限制,依照不同情境場合隨心更換喜愛的精油,進行空間的香氣管理。Bamboo 無水擴香儀採用專利靜音霧化技術,不需加水或加熱,即可直接使天然精油霧化,將自然芬芳香氣快速且均勻地送至空間中各個角落。以充滿東方文學內涵的竹子做為設計靈感,搭配極具質感淺灰色系機身,巧妙結合自然線條的洗鍊造型,時尚設計使擴香儀成為居家陳列藝術品。
BLOOMY LOTUS Macaron 馬卡龍超音波陶瓷香氛儀

另一款擴香機則以以法式點心「馬卡龍」為靈感,不僅形狀可愛,還有陶瓷工藝打造的復古魚骨紋設計,時髦清新的復古造型特別討喜。特大容量(290ml)水箱設計,可設定長達約16小時的運作模式,特別適合較大坪數的室內空間使用。
NEOM療癒香氛機MINI

上市以來備受喜愛的NEOM療癒香氛機,2021年9月全新推出迷你尺寸搭檔-NEOM療癒香氛機MINI。以MINI為名呼應便於隨身攜帶、隨心使用的迷你外型, 專為小型場域設計(例如居家工作的事務桌、更衣室、汽車內),短短幾分鐘內,讓源於植物精油的天然氣息,完美擴散於空氣當中,溫柔包覆每一個紓心時刻。

NEOM療癒香氛機MINI不需要透過加熱、加水,採用無水氣的冷擴散技術,可將喜愛的精油轉化為香氛細霧。機器可使用行動電源、車載充電器、電源插座或是USB介面的電腦進行充電,充電完成後即可不受線材限制,使用最多50小時,充分體現讓療癒香氣隨心而行的設計理念。使用後不需要逐次清洗的潔淨設計,更大幅提升使用便利性。同步推出裸色、黑色共2款色選,完美展現個人風格與時尚品味。
WASTE The New Normal氣味培養皿
台灣家居品牌WASTE推出了醞釀已久的擴香-The New Normal氣味培養皿。有別於一般常見的擴香石,The New Normal氣味培養皿看起來就像是將實驗室中的微觀世界。特別以春池玻璃研發的科技綠能建材「發泡玻璃」作為擴香擴香載體,不僅環保無毒,蜂巢狀孔洞也能達到很好的擴香效果。使用時滴入5~8滴精油即可讓香氣充滿空間,並附玻璃蓋子,可在不需擴香時減緩香氣的消耗。而且每一個培養皿都是純手工製作的。從培養皿內的顏色到暈染的花紋都不會重複,是獨一無二的存在。
延伸閱讀:
2021精油、擴香機新品推薦參考價錢
Oui Organic葡萄柚單方精油10ml,NT980
Oui Organic尤加利單方精油10ml,NT680
Oui Organic白千層單方精油10ml,NT680
Oui Organic依蘭依蘭單方精油10ml,NT780
Oui Organic乳香單方精油5ml,NT1,080
BLOOMY LOTUS B01思緒清晰配方精油10ml,NT1,050
BLOOMY LOTUS B02活力充沛配方精油10ml,NT1,050
BLOOMY LOTUS K01全神貫注寶貝配方精油10ml,NT1,050
BLOOMY LOTUS K02 頭好壯壯寶貝配方精油10ml,NT1,050
BLOOMY LOTUS K03 一夜甜睡寶貝配方精油10ml,NT1,050
Jurlique單方芳香精油(6款)10ml,NT950
Jurlique愜意舒心複方精油10ml,NT1,050
BLOOMY LOTUS Lava Rock火山岩擴香石,NT1,200
BLOOMY LOTUS ZEN禪隨身負離子擴香儀,NT2,780
BLOOMY LOTUS Pebble 隨身美肌香氛儀2.0,NT1,950
BLOOMY LOTUS Bamboo無水擴香儀2.0,NT2,850
BLOOMY LOOMY LOTUS Macaron馬卡龍超音波陶瓷香氛儀,NT3,800
BLOOMY LOOMY LOTUS Leaf葉超音波香氛儀,NT3,300
NEOM療癒香氛機MINI(兩色),NT2,200
免責聲明:肌膚保養品使用後狀況會依個人使用方法及肌膚狀況而有所不同,並請配合正確使用方法。

